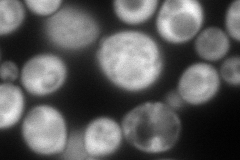
YKL060C
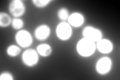
YKL060C

View description
Fructose 1,6-bisphosphate aldolase, required for glycolysis and gluconeogenesis; catalyzes conversion of fructose 1,6 bisphosphate to glyceraldehyde-3-P and dihydroxyacetone-P; locates to mitochondrial outer surface upon oxidative stress
Localization:
Intensity:
Fold change:
Significance:
-
C’ GFP library in SD

cytosol3740.95 -
N' NOP1pr-GFP in SD
cytosol327.937 -
N' TEF2pr-mCherry in SD

missing0 -
N' NATIVEpr-GFP in SD

cytosol22.367 -
N' TEF2pr-VC and Cyto-VN in SD

#N/A0 -
C’ GFP library in SD+DTT

cytosolN/AN/ANo -
C’ GFP library in SD+H2O2

cytosol3726.20.99No -
C’ GFP library in Starvation Media
cytosol3740.951No -
C’ GFP library on the background of Pup2-DaMP

cytosol -
C’ GFP library on the background of CCT mutant

cytosol3267.780.873515No
